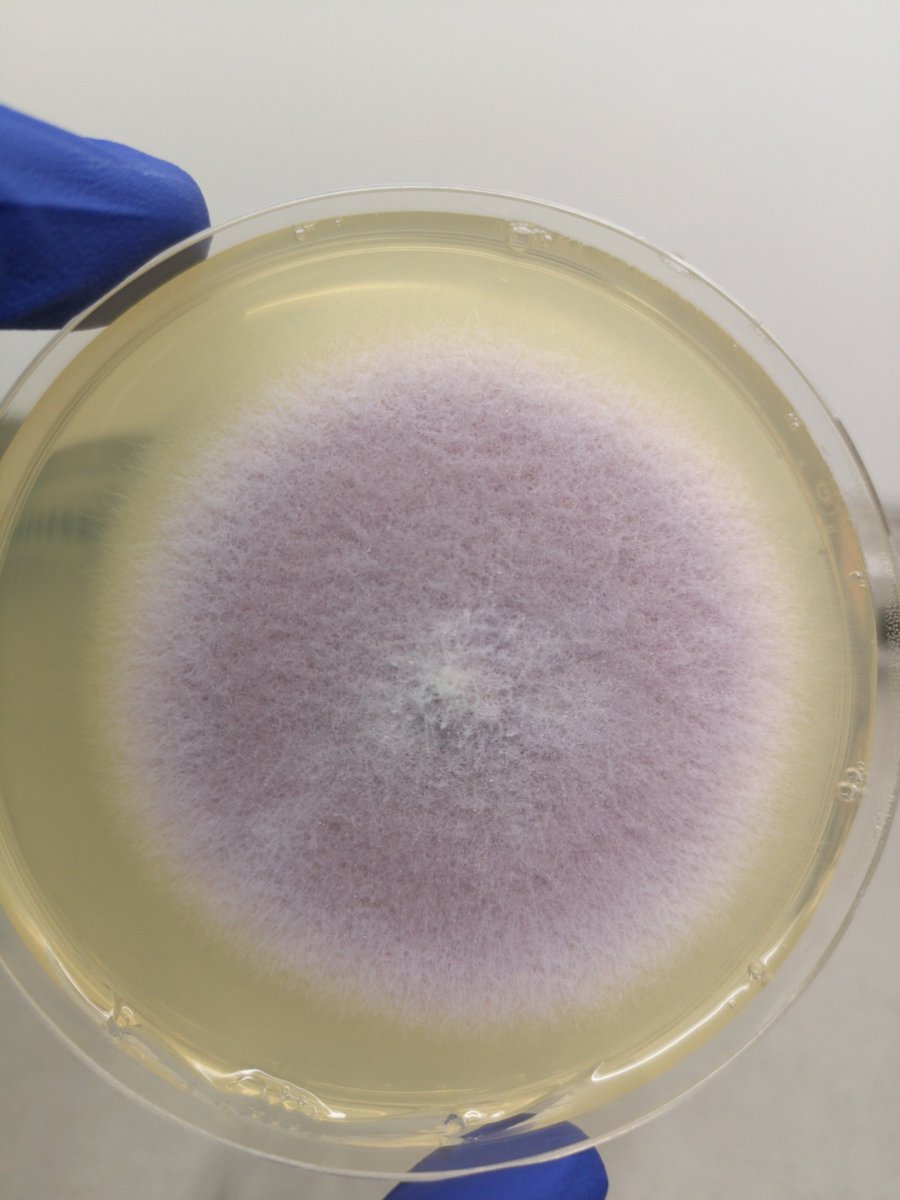
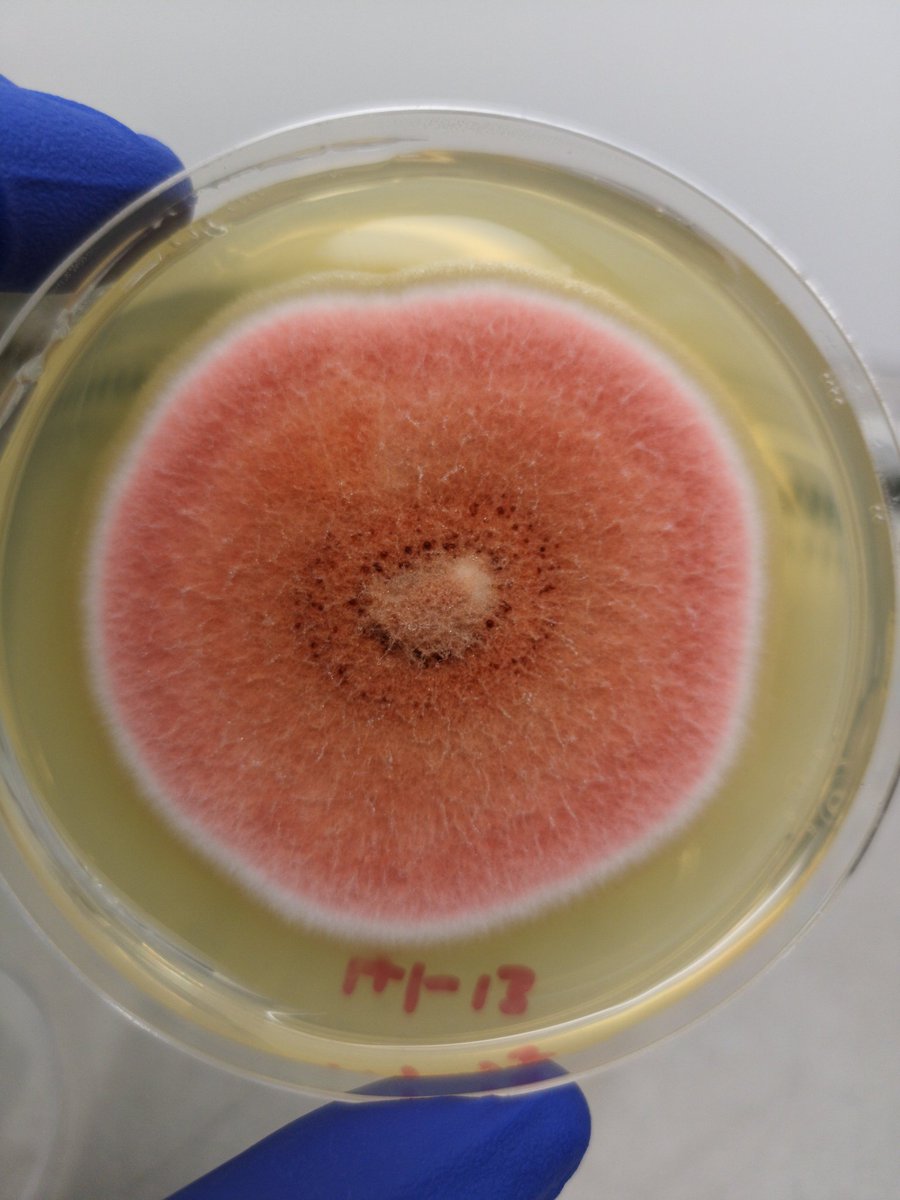

الموضوع شوية غريب وما اعتقد احد حطو في بالو قبل كدا او فكر فيه. استهلاك القهوة جدا عالي وخاصة فئة الشباب في الوقت الحالي. لكن لكن لكن، هل فكرتو يوم من الايام، مين المسؤول عن جودة وطعم البن (القهوة) وصحة النبات اللي بتنتج البن؟ 🙄 خلينا نشوف...
دراسات كتيرة اثبتت انه شرب القهوة جدا مفيد. من فوائد شربها:
- تقليل نسبة الدهون الضارة في الجسم
- تقليل الالتهابات في الجسم الناتجة عن السمنة
- حماية الدماغ و وظائف العقل في كبر الين
- حماية الشرايين عن طريق منع ترسبات الكالسيوم اللي ممكن تساعد في تكوين الجلطة
- حماية الكبد
- تقليل نسبة الدهون الضارة في الجسم
- تقليل الالتهابات في الجسم الناتجة عن السمنة
- حماية الدماغ و وظائف العقل في كبر الين
- حماية الشرايين عن طريق منع ترسبات الكالسيوم اللي ممكن تساعد في تكوين الجلطة
- حماية الكبد
- الحفاظ على مستوى السكر في الدم
وغير كدا، كتير دراسات اثبتت انو الناس اللي تشرب قهوة يوميا، عندهم البكتيريا النافعة في الجهاز الهضمي اكتر من البكتيريا الضارة. وهدا الشي زي ما قلت قبل كدا، مهم في هضم الاكل و محاربة الميكروبات الضارة.
وغير كدا، كتير دراسات اثبتت انو الناس اللي تشرب قهوة يوميا، عندهم البكتيريا النافعة في الجهاز الهضمي اكتر من البكتيريا الضارة. وهدا الشي زي ما قلت قبل كدا، مهم في هضم الاكل و محاربة الميكروبات الضارة.
طيب، هل كل الفوائد دي حقت القهوة مرتبطة بجودة القهوة؟
طبعا الجواب: نعم. كل ما كانت جودة القهوة اعلى، كل ما كانت فوائدها اكثر. يعني لحد يشتري قهوة رخيصة ويقول والله مفيدة😅، طبعا الفوائد اللي فيها تكون اقل بكتير وحتى الطعم راح يفرق اكيد.
طبعا الجواب: نعم. كل ما كانت جودة القهوة اعلى، كل ما كانت فوائدها اكثر. يعني لحد يشتري قهوة رخيصة ويقول والله مفيدة😅، طبعا الفوائد اللي فيها تكون اقل بكتير وحتى الطعم راح يفرق اكيد.
في انواع خاصة من البكتيريا والفطريات تكون موجودة حولين جذور نبتة البن، تساعدها في الحصول على الفيتامينات والمعادن الاساسية لنمو النبتة وتحافظ على صحتها وانتاجها. وغير كدا بتحمي الجذور من ميكروبات تانية وحشرات ممكن تقتل نبتة البن.
يعني اذا كان عندنا ارض خصبة ونبتة البن، لكن بدون البكتيريا والفطريات، هل ممكن النبتة دي تكبر؟ اترك الجواب لكم...
بعد ما كبرت النبتة واثمرت البن، ايش يصير لثمار البن عشان يكون جاهز للبيع والاستهلاك؟ طبعا المزارعين يجمعو الثمار ويزيلو القشرة الخارجية عشان يطلعو البن اللي داخل الثمرة.
الجواب، نعم سهل ازالة المادة دي، لكن فقط عن طريق البكتيريا والفطريات بطريقة اسمها التخمير.
التخمير عبارة عن تفاعل يصير مع البن في وجود البكتيريا والفطريات اللي بدورها تفرز مواد و انزيمات خاصة تحلل المادة اللي حولين البن.
التخمير عبارة عن تفاعل يصير مع البن في وجود البكتيريا والفطريات اللي بدورها تفرز مواد و انزيمات خاصة تحلل المادة اللي حولين البن.
عملية التخمير عادة تكون من يوم الى يومين على حسب عدة عوامل. اذا كانت عملية التخمير اقل من الوقت المطلوب، راح تكون جودة القهوة سيئة.
وكمان اذا اخدت عملية التخمير اكتر من اللازم، القهوة حرفيا تصير حامضة وتتعفن وتنمو عليها فطريات وبكتيريا ضارة.
وكمان اذا اخدت عملية التخمير اكتر من اللازم، القهوة حرفيا تصير حامضة وتتعفن وتنمو عليها فطريات وبكتيريا ضارة.
البن فيه اكتر من ٧٠٠ مركب يساهمو في طعم القهوة. عشان كدا عملية التخمير باستخدام الميكروبات جدا مهمة للحفاظ على جودة البن. ومهمة كمان حتى في انتاج نكهات مختلفة من القهوة عن طريق استخدام انواع معينة من الفطريات والبكتيريا.
الميكروبات دي جدا مهمة في انتاج القهوة.
الميكروبات دي جدا مهمة في انتاج القهوة.
جاري تحميل الاقتراحات...